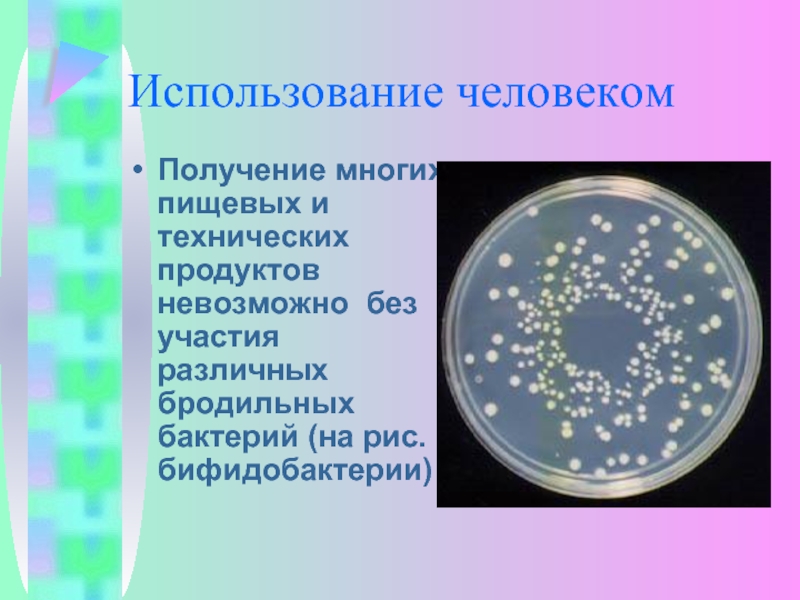

- Главная
- Разное
- Дизайн
- Бизнес и предпринимательство
- Аналитика
- Образование
- Развлечения
- Красота и здоровье
- Финансы
- Государство
- Путешествия
- Спорт
- Недвижимость
- Армия
- Графика
- Культурология
- Еда и кулинария
- Лингвистика
- Английский язык
- Астрономия
- Алгебра
- Биология
- География
- Детские презентации
- Информатика
- История
- Литература
- Маркетинг
- Математика
- Медицина
- Менеджмент
- Музыка
- МХК
- Немецкий язык
- ОБЖ
- Обществознание
- Окружающий мир
- Педагогика
- Русский язык
- Технология
- Физика
- Философия
- Химия
- Шаблоны, картинки для презентаций
- Экология
- Экономика
- Юриспруденция
Прокариотическая клетка презентация
Содержание
- 1. Прокариотическая клетка
- 2. Бактерии – «великие могильщики природы» Луи Пастер.
- 4. Происхождение прокариот Первоначально появились в бескислородной среде 2,5-3 млрд. лет назад в морях
- 5. Среда обитания прокариот Атмосфера Гидросфера Литосфера Внутри клеток
- 6. Размеры Размеры бактериальных клеток колеблются в пределах от 1 до 10-15 мкм
- 7. Форма Кокки Диплококки Тетракокки
- 8. Форма Стрептококки
- 9. Форма Сарцины Стафилококи Палочки (бациллы)
- 10. Форма Спириллы Спирохеты Вибрионы
- 11. Строение бактериальной клетки На поверхности бактерий часто
- 12. Строение бактериальной клетки 1 — клеточная стенка,
- 13. Строение бактериальной клетки Клеточная стенка прокариот жесткая,
- 14. Строение бактериальной клетки Основная особенность – отсутствие
- 15. Обмен веществ По отношению к кислороду прокариоты
- 16. Питание По способам питания делятся на: автотрофы
- 17. Бактерии-паразиты Паразиты – это бактерии, которые питаются
- 18. Размножение У бактерий выделяют два способа размножения: путем деления клетки надвое и половой
- 19. Спорообразование Многим бактериям свойственно спорообразование. Споры возникают,
- 20. Роль в природе А) Бактерии разрушают остатки
- 21. Использование человеком Получение многих пищевых и технических
- 22. Отрицательная роль бактерий Различные виды гнилостных бактерий
- 23. Почему Луи Пастер назвал прокариотические организмы – великими могильщиками в природе?
- 24. Какие ощущения вы испытываете при изучении этой темы?
Слайд 2Бактерии – «великие могильщики природы»
Луи Пастер.
Эти маленькие организмы создали жизнь на
Земле, совершают глобальный круговорот веществ в природе, а также стоят на службе у человека.
Слайд 4Происхождение прокариот
Первоначально появились в бескислородной среде 2,5-3 млрд. лет назад в
морях
Слайд 11Строение бактериальной клетки
На поверхности бактерий часто заметны разного рода жгутики (пилли)
и ворсинки (фимбии) – органоиды движения, с помощью которых они передвигаются путем скольжения.
Слайд 12Строение бактериальной клетки
1 — клеточная стенка,
2 — наружная цитоплазматическая мембрана,
3 — хромосома (кольцевая молекула ДНК),
4 — впячивание наружной цитоплазматической мембраны,
5 — вакуоли,
6 — мезосома (вырост наружной мембраны),
7 — стопки мембран, в которых осуществляется фотосинтез,
8 — рибосома,
9 — жгутики.
Слайд 13Строение бактериальной клетки
Клеточная стенка прокариот жесткая, содержит полисахариды и аминокислоты. Основной
упрочняющий компонент – муреин Клеточная стенка многих бактерий сверху покрыта слоем слизи.
Цитоплазма окружена мембраной, отделяющей ее изнутри от клеточной стенки.
Цитоплазма окружена мембраной, отделяющей ее изнутри от клеточной стенки.
Слайд 14Строение бактериальной клетки
Основная особенность – отсутствие ядра, ограниченного оболочкой. Наследственная информация
у бактерий заключена в одной хромосоме.
Рибосомы свободные меньше, чем у эукариотов; на них осуществляется биосинтез белка
Рибосомы свободные меньше, чем у эукариотов; на них осуществляется биосинтез белка
Слайд 15Обмен веществ
По отношению к кислороду прокариоты делятся на две группы:
анаэробные (не
нуждающиеся в кислороде);
аэробные, (живущие в кислородной среде);
некоторые бактерии могут жить как в бескислородной, так и в кислородной средах
аэробные, (живущие в кислородной среде);
некоторые бактерии могут жить как в бескислородной, так и в кислородной средах
Слайд 16Питание
По способам питания делятся на:
автотрофы - получают энергию за счет фотосинтеза
(цианобактерии) и хемосинтеза (железобактерии, азотобактер, пурпурные серобактерии);
гетеротрофы –получают энергию за счет готовых органических веществ. Гетеротрофы, в свою очередь, подразделяются на сапротрофы, паразиты и симбионты.
гетеротрофы –получают энергию за счет готовых органических веществ. Гетеротрофы, в свою очередь, подразделяются на сапротрофы, паразиты и симбионты.
Слайд 17Бактерии-паразиты
Паразиты – это бактерии, которые питаются за счет клеток живых организмов,
вызывая заболевания (мучнистая роса, виноградная филлоксера, палочка Коха (туберкулезная), столбнячная палочка, дизентерийная палочка, холерный вибрион и др.)
Слайд 18Размножение
У бактерий выделяют два способа размножения: путем деления клетки надвое и
половой
Слайд 19Спорообразование
Многим бактериям свойственно спорообразование. Споры возникают, когда ощущается недостаток в питательных
веществах или когда в среде накапливаются продукты обмена, т.е. возникают неблагоприятные условия
Слайд 20Роль в природе
А) Бактерии разрушают остатки органического вещества, производят минерализацию.
Б)
Бактерии – симбионты (кишечная палочка), поселяясь в пищеварительном тракте у животных, расщепляют целлюлозу до глюкозы, и обеспечивает усвоение этих веществ организмом животных, производят витамины и другие вещества.
В) Азотфиксирующие (клубеньковые) бактерии способствуют усвоению почвенного азота корнями растений.
В) Азотфиксирующие (клубеньковые) бактерии способствуют усвоению почвенного азота корнями растений.
Слайд 21Использование человеком
Получение многих пищевых и технических продуктов невозможно без участия различных
бродильных бактерий (на рис. бифидобактерии)
Слайд 22Отрицательная роль бактерий
Различные виды гнилостных бактерий вызывают порчу пищевых продуктов. Сальмонеллез,
ботулизм, холера дизентерия, являются заболеваниями, связанными с употреблением испорченных продуктов.
Коклюш, туберкулез, чума, венерические заболевания, столбняк, воспаление легких и многие другие передаются воздушно – капельным или половым путем.
Коклюш, туберкулез, чума, венерические заболевания, столбняк, воспаление легких и многие другие передаются воздушно – капельным или половым путем.